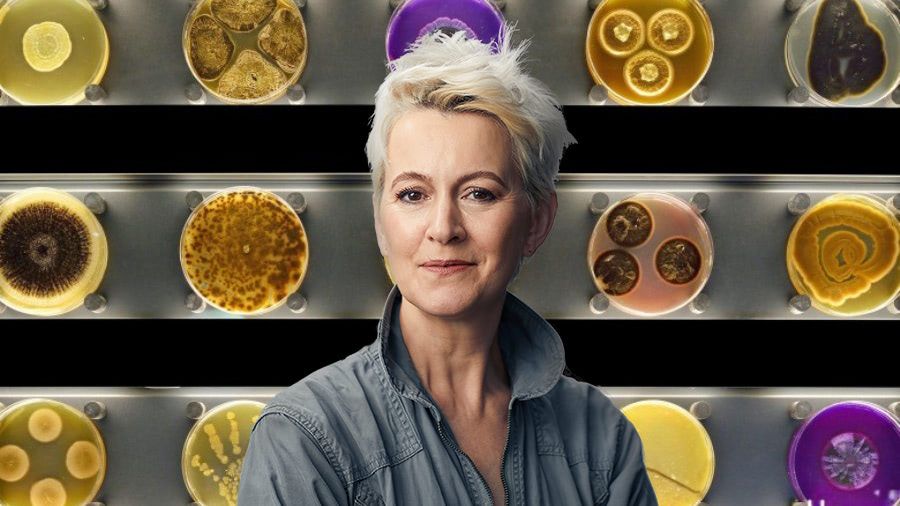
Visual of Suzanne Lee wants to live in a world that uses only sustainable materials

Bio Design
A happy marriage between biology and technology
Bio design crosses the border between the ‘made’ and the ‘born’. Enabling living organisms as essential design elements, it bring us products that adapt, grow, sense and repair themselves. Industrial and mechanical systems are replaced with biological processes. Bio design overtakes imitation and biomimicry, completely dissolving the boundaries between organisms and objects. A happy marriage between biology and technology.
Staff Picks

Why bio is the new digital
Here's MIT Media Lab director Joi Ito explaining how biotech is rapidly becoming more accessible to creative people outside of closed institutions, drawing parallels to the democratization of computers some decades ago. Be sure to watch the video until his last sweeping sentence "The design of the future is hardware, it's software, it's biology and it's complex.. But you have to know math."
Artifice Earth: Adam Rutherford on the Promises of Synthetic Biology
In the basement recording studio of the journal Nature scientist and broadcaster Adam Rutherford sat down with speculative architect Liam ...
Suzanne Lee wants to live in a world that uses only sustainable materials
Biotechnology is nearly as old as humanity itself. The food you eat and the pets you love? You can thank ...
Interview: Alexandra Daisy Ginsberg, Designer and Synthetic Biology Expert
The next guest in our interview series is Alexandra Daisy Ginsberg a designer artist and writer. Daisy Ginsberg explores the social ...